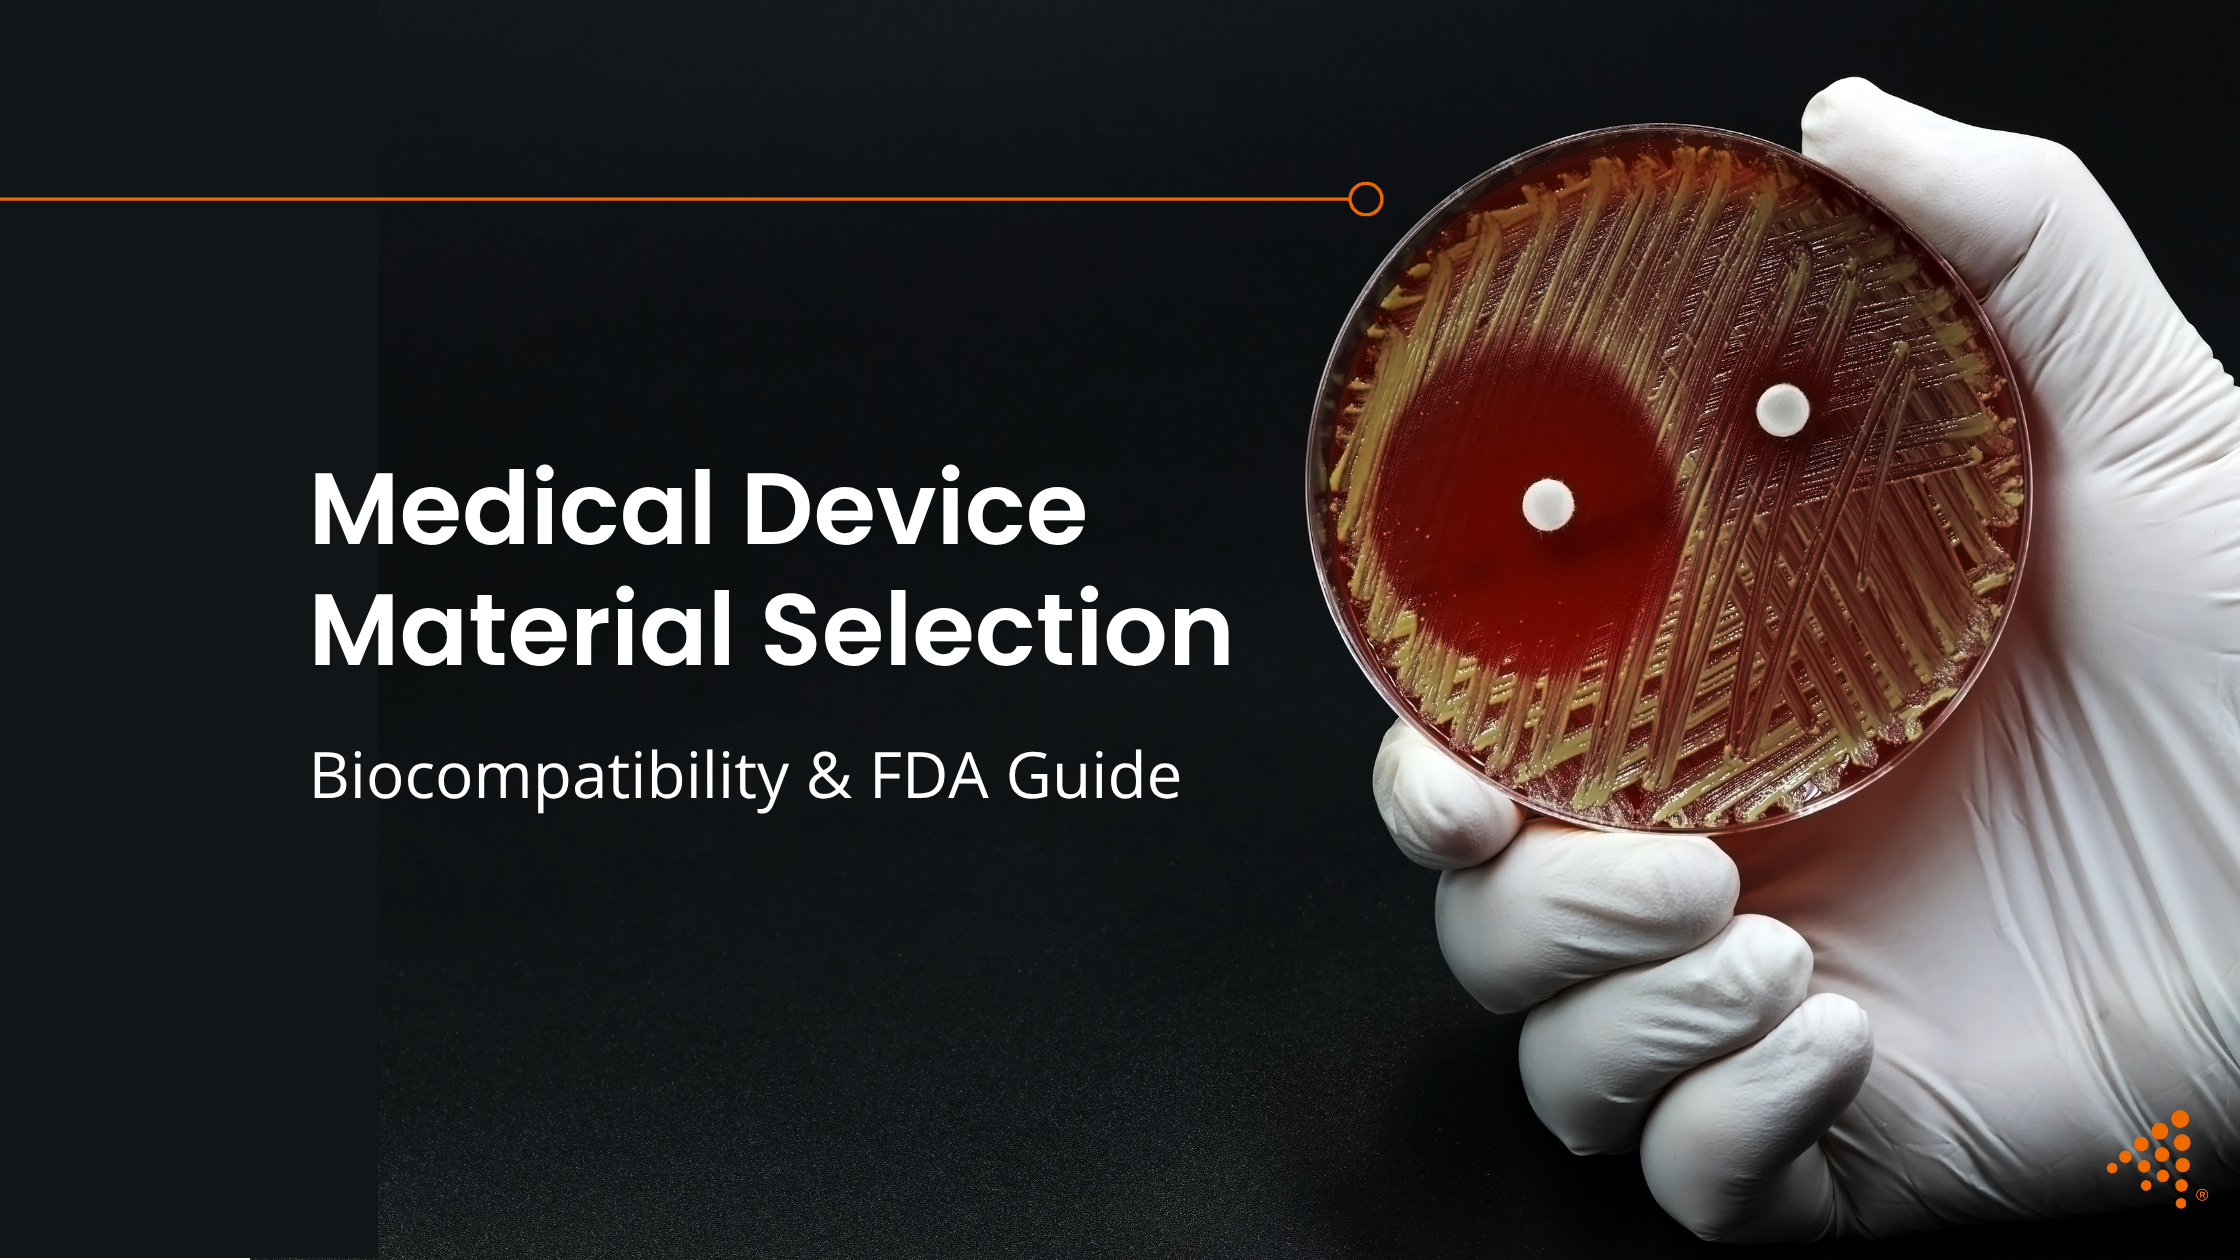
Medical Device Material Selection: Biocompatibility & FDA Guide

Tight Tolerance Injection Molding: Material Selection Guide
Achieving exceptionally tight tolerances in injection molded parts is a hallmark of quality and precision, particularly in industries where every...
4 min read
Nick Erickson : Dec 6, 2025 8:00:00 AM
The selection of the right material is a foundational step in the design and manufacture of any medical device. For products that will come into contact with the human body, the material's interaction with tissue and fluids is a primary consideration for patient safety. This is where the concepts of biocompatibility and regulatory approval become paramount. Choosing a plastic resin that not only meets the functional requirements of the device but also adheres to stringent safety standards is a complex but essential part of the product development journey. This guide will explore the key considerations for selecting injection molding materials for medical applications, focusing on biocompatibility, FDA recognition, and suitability for sterilization.
Working with a plastic injection molding company that offers design for manufacturing services and plastic injection mold design services helps align material selection with both regulatory and manufacturing requirements.
Read More About Maximizing Mold Longevity with the Aprios Maintenance Strategy
Before a medical device can be brought to market, its materials must be proven safe for their intended use. Several standards and regulatory bodies provide the framework for this verification. The U.S. Food and Drug Administration (FDA) is the primary regulatory body in the United States, and it recognizes several key standards for evaluating the biocompatibility of materials.
One of the most important of these is the International Organization for Standardization (ISO) 10993, Biological evaluation of medical devices. This comprehensive set of standards outlines a risk-based approach to determine if a material is safe for its intended application. The testing required under ISO 10993 depends on the nature and duration of the device's contact with the body.
Another widely recognized benchmark is the United States Pharmacopeia (USP) Class VI classification. This standard involves a series of in vivo tests to assess the biological reactivity of plastic materials. To achieve a USP Class VI designation, a material must exhibit a very low level of toxicity and biological reactivity, making it a good candidate for medical applications. While USP Class VI is a strong indicator of a material's suitability, it is important to remember that it is the final, sterilized device that must be proven biocompatible, not just the raw material.
For manufacturers, using FDA Injection Molding, ISO-Certified Manufacturing, and proven injection molding quality control systems ensures safer, compliant outcomes.
Planning a New Medical Device?
Work with experts in design for manufacturing solutions and injection molding tooling to ensure compliance and performance.
A range of high-performance plastics has been developed to meet the demanding requirements of the medical industry. The choice of material will depend on the specific needs of the device, including its strength, chemical resistance, transparency, and ability to withstand sterilization.
Polypropylene is a versatile and cost-effective polymer widely used in medical devices. Medical-grade PP offers a good balance of physical properties, chemical resistance and is generally considered to have good biocompatibility. It is frequently used for disposable items such as syringes, connectors, and containers. Certain grades of polypropylene can also be autoclaved, making them suitable for reusable devices that require steam sterilization.
Polyethylene, particularly in its high-density (HDPE) and low-density (LDPE) forms, is another common choice for medical applications. It is known for its flexibility, moisture resistance, and biocompatibility. LDPE is often used in squeezable bottles and tubing, while HDPE is found in more rigid containers and components.
Polycarbonate is prized for its exceptional strength, impact resistance, and transparency. This makes it an ideal material for applications where visibility is important, such as in housings for dialysis filters or surgical instruments. Medical-grade polycarbonate can be sterilized using methods like ethylene oxide (EtO) and radiation, and some grades are formulated to withstand autoclaving, although repeated steam sterilization can sometimes lead to a loss of clarity and strength.
For the most demanding medical applications, particularly those involving implants, Polyetheretherketone (PEEK) is a top-tier choice. This high-performance thermoplastic offers a unique combination of strength, stiffness, chemical inertness, and resistance to high temperatures. PEEK can withstand numerous sterilization cycles, including steam autoclaving, without significant degradation of its properties. Its bone-like modulus of elasticity also makes it a favored material for spinal and orthopedic implants.
Polysulfone and its close relative, polyphenylsulfone, are high-performance thermoplastics known for their excellent hydrolytic stability and toughness, even at elevated temperatures. These materials can endure repeated steam sterilization cycles, making them well-suited for reusable medical instruments and trays. Radel®, a trade name for PPSU, is particularly known for its ability to withstand over 1,000 autoclave cycles without significant loss of properties.
The use of DFM for Medical Devices and plastic part design optimization ensures that these materials perform reliably during both manufacturing and clinical use.
The chosen method of sterilization will have a significant influence on the material selection process. It is not enough for a material to be biocompatible in its raw state; it must maintain its integrity and safety after undergoing sterilization.
Autoclaving uses high-pressure steam at temperatures typically ranging from 250°F (121°C) to 273°F (134°C). This method is effective and economical, but it can degrade materials that are not heat-resistant. PEEK, PPSU, and certain grades of polycarbonate and polypropylene are well-suited for autoclaving.
EtO is a low-temperature gas sterilization method that is ideal for heat-sensitive plastics. It is highly effective but requires a lengthy aeration process to remove residual gas. Many plastics, including PVC, polyethylene, and polycarbonate, are compatible with EtO sterilization.
Radiation sterilization uses gamma rays or high-energy electrons (E-beam) to kill microorganisms. This is a "cold" process, making it suitable for a wide range of plastics. However, radiation can cause some polymers to become brittle or change color. Careful material selection and testing are necessary to ensure compatibility.
Here, early validation through Rapid Prototyping Services, Medical Device Prototypes, and 3D Printed Prototypes can reduce risk before moving into Custom Injection Molding Solutions.
Read More About Optimizing Mold Design for Efficient Injection Molding
Choosing the right material for a medical device is a multifaceted process that requires a deep understanding of regulatory requirements, material science, and manufacturing processes. The safety and efficacy of the final product depend on making an informed decision at this initial stage.
At Aprios, we have extensive experience in working with a wide range of medical-grade plastics and can guide you through the material selection process. Our expertise in injection molding tooling, design for manufacturing solutions, and end-to-end manufacturing services ensures that your parts are produced to the highest standards, meeting all regulatory and functional requirements. If you're ready to discuss your next medical device project, contact Aprios today to learn how we can support you from concept to production.
You can also view our Material Selection tool.

Achieving exceptionally tight tolerances in injection molded parts is a hallmark of quality and precision, particularly in industries where every...

To protect patients, medical instruments must be free from viable microorganisms. However, the very methods used to achieve sterility can have...

Low-Density Polyethylene (LDPE) is a flexible, cost-effective thermoplastic resin commonly used in a variety of industries. Known for its pliability,...